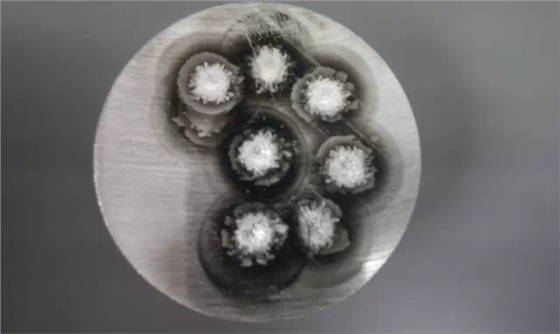
光譜標(biāo)樣

樣品在激發(fā)時,激發(fā)的點何為正常?何為非正常?如果出現(xiàn)非正常的情況,我們該從那幾個下面去查找原因呢?這一系列困惑大家的問題,你都將從下面找到答案。


*濃縮(凝聚)放電—激發(fā)點中心處侵蝕均勻并有金屬光澤,此為正常放電,表明儀器工作正常。

Fe基樣品正常激發(fā)斑點
影響激發(fā)點不正常的因素:
•氬氣質(zhì)量不達(dá)標(biāo)。

2025年04月21日14:14
樣品在激發(fā)時,激發(fā)的點何為正常?何為非正常?如果出現(xiàn)非正常的情況,我們該從那幾個下面去查找原因呢?這一系列困惑大家的問題,你都將從下面找到答案。


*濃縮(凝聚)放電—激發(fā)點中心處侵蝕均勻并有金屬光澤,此為正常放電,表明儀器工作正常。
Fe基樣品正常激發(fā)斑點
影響激發(fā)點不正常的因素:
•氬氣質(zhì)量不達(dá)標(biāo)。
什么是能量色散X射線熒光光譜儀德國斯派克直讀光譜分析儀的使用環(huán)境及安裝條件壓鑄件設(shè)計工藝-直讀光譜儀X射線熒光光譜儀在冶金分析中的應(yīng)用手持光譜儀對人體有輻射嗎?